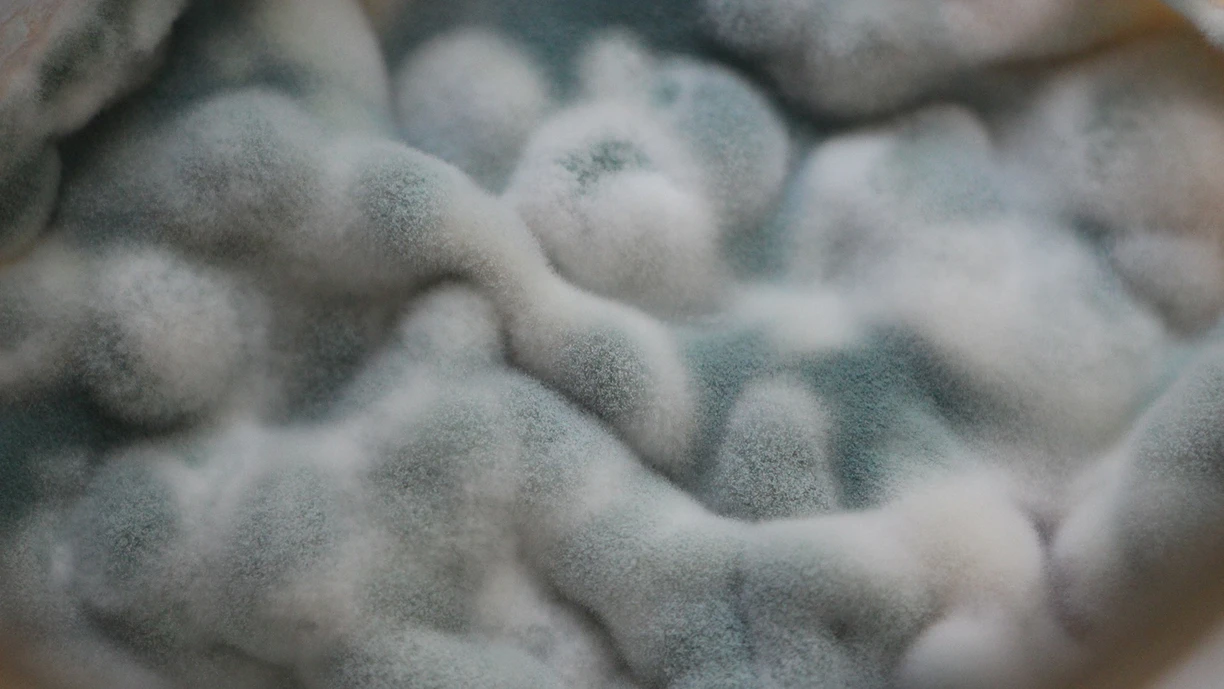
east and mold growing and limiting the shelf life of a particular dairy product

Next-level shelf-life extension for fermented milk
From reduced waste and costs to lower carbon emissions, shelf-life extension delivers benefits across your value chain. All while preserving the quality consumers love.
What limits the shelf life of fermented milk?
How to increase the shelf life of yogurt? It’s a complex question, because shelf life can be limited by several factors. With Novonesis’ FreshQ® bioprotective cultures you can inhibit the outgrowth of yeast and mold and improve freshness with minimal impact on post-acidification. That helps you to overcome the challenges outlined below.

Fungal spoilage
The first sign of fungal spoilage might be blown packaging. Or it could be a strong yeasty or moldy flavor in the yogurt. It could even be visible growth.

Flavor deterioration
Over time, fermented milk products can develop off flavors. This can be due to yeast spoilage, which – even at low levels - can impact flavor.

Post-acidification
From sourness to syneresis, acidity continuing to develop after fermentation can alter the flavor and texture of fermented milk in a number of ways.
Spoiler alert!
It’s a tale as old as time – yeast and mold versus good bacteria in the battle to keep fermented milk products from spoiling. But now there’s a twist.
FreshQ® gives the good bacteria the upper hand to help reduce waste. Now that’s a powerful sustainability story where the good guys win for a change.
Next level dairy.
Get closer to your environmental impact goals
Dairy companies have responded to the climate challenge with ambitious greenhouse gas (GHG) reduction goals. Reaching your goals will take emissions savings in every part of your value chain. Dairy is one of the food categories that’s wasted most, so waste reduction is a great place to start.
of dairy is wasted globally1
of yogurt is wasted in Europe
of waste is due to shelf-life issues
What if all European yogurts contained FreshQ®?
Shelf-life could be extended by seven days
Our study indicates that dairy manufacturers would gain an extra day’s shelf life, while retailers and consumers would benefit from the remaining six days1. The study also indicates that seven days is a conservative estimate.

Yogurt waste could be reduced by 30%
Annual yogurt waste could be reduced by 30%. This would be a clear benefit to the environment. And consumers would also benefit, as extending shelf life for yogurt should translate into significant savings in household budgets.

CO2 emissions could be reduced by 520,000 tons
Producing, distributing and storing one kilo of yoghurt is associated with around 1.2 to 1.3 kilo of CO2 emissions, depending on yogurt type. So reducing yogurt waste by 30% could reduce CO2 emissions by up to 520,000 tons.

FreshQ® for next-level value chain benefits

Production
FreshQ® optimizes your production efficiency in a range of ways. It allows you to increase your batch volume. It also gives you more flexibility so you can better cope with demand volatility.
And with FreshQ®, you can reduce frequency of batch changeovers, production costs and waste.

Logistics
The extra shelf life FreshQ® helps you achieve allows you to increase bulk picking and decrease piece picking. It also allows for larger average shipping case sizes. That reduces your shipping to retailers, with larger, less frequent batches of each SKU. All these benefits support optimized logistics.

Export
With longer shelf life, you can potentially expand your market reach to geographically distant cities, regions or even countries. These new market opportunities are especially relevant to regions with limited cold chain infrastructure and varying storage conditions.

Retailer
The additional days of shelf life FreshQ® helps you get optimizes retailer logistics by reducing the risk of your products going out of stock. They also reduce your risk of having to carry the costs of expiration-related waste.

Consumer
Consumers love delicious fermented dairy. They also love convenience. And they’re looking for ways to cut down on food waste in their homes. With FreshQ®, you can give them everything they want and boost their positive perception of your brands.
Want to build and protect your yogurt brand?
Keep your yogurt in ideal condition so it can stand out from the competition with FreshQ®.
Extended shelf life with low post-acidification
Longer shelf life can come with unwanted post-acidification. Avoid unwanted post-acidification by combining a low post-acidifying starter culture like Novonesis’ YoFlex®, Novonesis’ eXact® or a blend like Novonesis’ Nu-trish® with FreshQ® in fermentation. That helps you keep fermented dairy products fresh for longer, with no compromise on taste. Naturally.

Biosolutions for shelf-life extension

- Extend shelf life
- Stay fresh
- Take control
- Go natural

- Superior pH stability
- Cost reduction in a warm filling process
- Mild base for your product innovation

- High texture achieved naturally
- Mild flavor throughout prolonged shelf life
- Increased flexibility in production
We also have biosolutions for shelf-life extension in cheese. By tackling waste, they help get more from cheesemaking inputs.
Let’s take shelf life to the next level together
Fill in the form below and one of our fermentation-enabled bioprotection specialists will get back to you.
One more step…
To complete the get in touch form or sign up, please click on the button below to enable cookies.